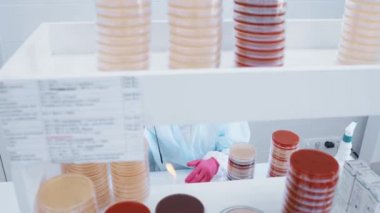
Bakteriyoloji laboratuvarında çalışan bilim adamı ya da işçiler birçok petri kabının arka planına karşı testler ve analizler yapar..

İhlal Bildirim Formu
En Çok Aranan Kelimeler
GrupdonanımTabakİlaç.TıbbiteknolojiEl.KlinikDoktorTest etHastalıkkültürörnekbiyolojiKimyasalDeneyLaboratuvarvirüsBakterikimyatakım çalışmasıaraştırmaanalizBilimselmikroorganizmaMikropbiyokimyaBiyoteknoloji.bilim adamıBakterilerDNAMikrobiyolojiÇalışan.salgınbilim adamlarıbiyomedikaltıbbi araştırmaBilimPetri yemeklerbiyolojik hücreleriBenzer İçerikler